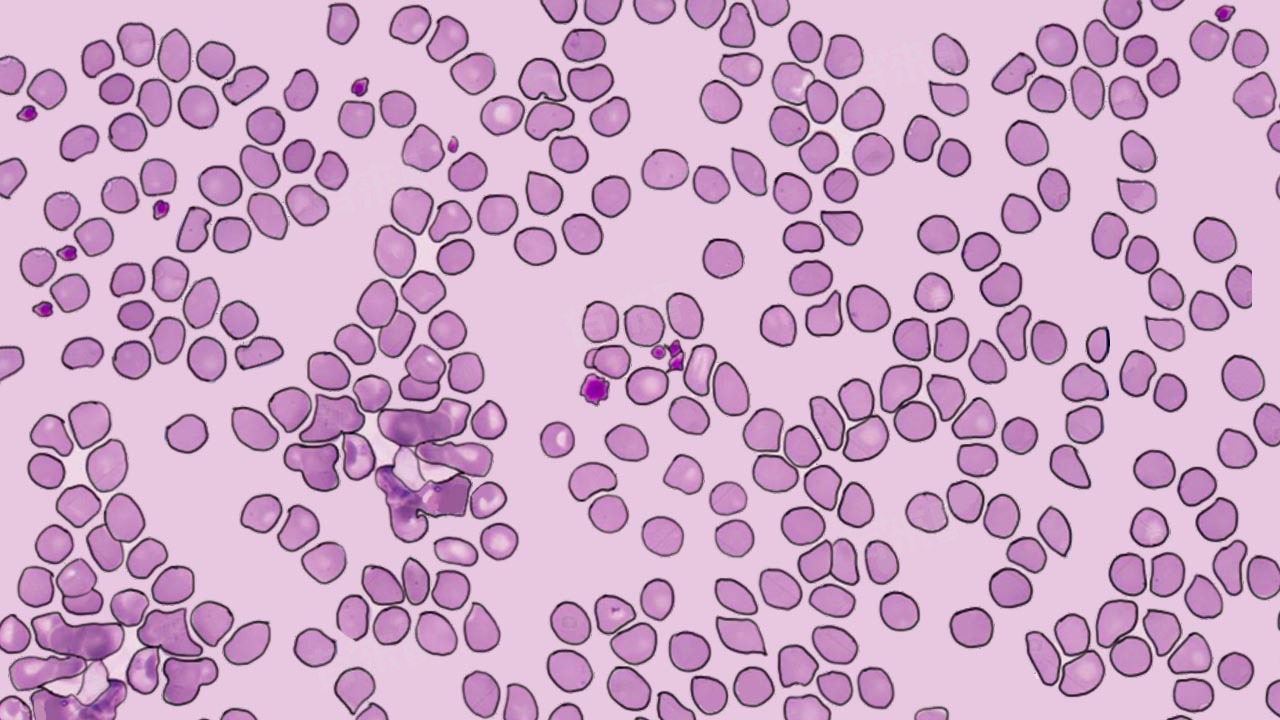

大型血小板比率低通常指大型血小板占总的血小板的比例低于正常范围,反映出血小板的某些特性和可能存在的健康问题。其原因可能包括营养不良、药物影响、脾功能亢进、免疫性血小板减少性紫癜等。
1、营养不良:可能导致血小板生成减少,通过合理饮食,增加富含维生素和蛋白质的食物摄入,如苹果、鸡蛋、瘦肉等,有助于改善血小板生成。
2、药物影响:某些药物如抗生素、抗病毒药物等可能导致血小板生成减少,停用这些药物后血小板数量可能会恢复正常。
3、脾功能亢进:脾脏具有产生免疫抗体、吞噬异物颗粒、剔除无用细胞、蓄积细胞及血小板的作用。脾功能亢进时,脾脏会过度破坏血小板,导致外周血血小板数量减少,大型血小板比率也会降低。
4、免疫性血小板减少性紫癜:这属于一类获得性自身免疫性疾病,血小板遭到免疫性破坏,导致外周血中血小板减少,进而出现大型血小板比率低的现象。
5、弥散性血管内凝血:在许多疾病基础上,致病因素损伤微血管体系,导致凝血活化,全身微血管血栓形成,凝血因子大量消耗并继发纤溶亢进,引起以出血及微循环衰竭为特征的临床综合征。这种情况下,血小板会被大量消耗,导致大型血小板比率降低。
6、再生障碍性贫血:这是一种可能由不同病因和机制引起的骨髓造血功能衰竭症,主要表现为骨髓造血功能低下、全血细胞减少,包括血小板数量减少,进而导致大型血小板比率降低。
7、骨髓增生异常综合征:骨髓干细胞异常,导致血小板生成减少,也会出现大型血小板比率偏低的情况。
大型血小板比率偏低本身并不是一种独立的疾病,而是可能由多种原因引起的。因此,在出现这种情况时,应及时就医并进行全面检查以明确病因。

